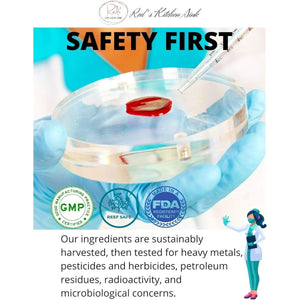
Red'S Kitchen Sink Cell Fuel 102: Sea Moss Powder | Organic Sea Moss, Bladderwrack & Burdock Root Herbal Blend 1 PACK - Suppviv

Red'S Kitchen Sink Cell Fuel 102: Sea Moss Powder | Organic Sea Moss, Bladderwrack & Burdock Root Herbal Blend 1 PACK
Estimate delivery times: 4-7 Days (United States).
We are confident that you will love your purchase, but if for any reason you are not completely satisfied, we offer Return within 60 days of purchase.
Guarantee Safe Checkout

Red'S Kitchen Sink Cell Fuel 102: Sea Moss Powder | Organic Sea Moss, Bladderwrack & Burdock Root Herbal Blend 1 PACK
Description
Red's Kitchen Sink Cell Fuel 102: Sea Moss Powder
A superfood powder packed with nutrients designed to support energy, immune health, and whole-body vitality.
Nutritional Powerhouse – Sea Moss
Red's Kitchen Sink Cell Fuel 102: Sea Moss Powder offers a holistic approach to wellness. This natural source of vitamins, minerals, and antioxidants supports daily energy, immune function, and vitality.
Key Features
- 100% All-Natural Sea Moss Powder: Sustainably harvested for maximum health benefits.
- Rich in Minerals: Contains iodine, potassium, and magnesium to promote balance and energy.
- Antioxidant Protection: Combats oxidative stress and supports healthy cells.
- Vegan & Gluten-Free: Clean, plant-based ingredients for everyone.
- Versatile Use: Mix into smoothies, teas, or recipes for effortless supplementation.
Why Choose Red's Kitchen Sink Cell Fuel 102?
An all-natural, multi-faceted approach to wellness. Supports energy, immune system health, and overall vitality.
Directions for Use
Add 1 teaspoon of sea moss powder to water, smoothies, or recipes daily. Adjust servings as necessary.
Order Red's Kitchen Sink Cell Fuel 102 Now
Step up your nutrition game with Red's Kitchen Sink Cell Fuel 102: Sea Moss Powder. Click "Add to Cart" today!